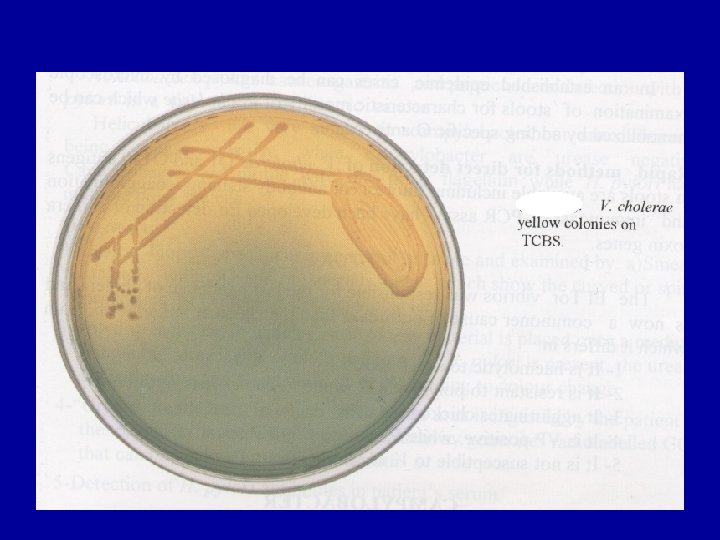

CHOLERA Vibrio cholerae Dr Salma Gram Negative Curved

CHOLERA Vibrio cholerae Dr. Salma

Gram Negative Curved Bacilli There are certain microorganisms that share this type of morphology which is sometimes is described as comma-shaped. The following m. o. are curved gram negative bacilli: 1. Vibrio. 2. Aeromonas. 3. Plesiomonas. 4. Campylobacter. 5. Helicobacter

Characteristics of Gram Negative Curved Bacilli: These m. o. are: 1. Gram negative curved bacilli. 2. Motile by a single polar flagellum. 3. Many live in fresh water, and some in sea water (called marine m. o. ). 4. Some of these m. o. can cause diarrhoea in humans.

Vibrio species (cont’d) Gram stain Curved design



Family: Vibrionacea Genus : Vibrio Genus Vibrio is classified practically into 10 important species: 1. Vibrio cholerae : Causes epidemic and pandemic cholera. 2. Non-cholera Vibrios: Cause ear, wound, soft tissue, and extra-intestinal infections. The important species of this group of m. o. are: V. mimicus, V. vulnificus, V. hollisae*, V. fluvialis*, V. damsela*, V. furnissi*, V. alginolyticus, V. metschnikovii. • = Group F Vibrio. 3. Vibrio parahaemolyticus: Causes gastroenteritis, and possibly extra-intestinal infections.

Species of Vibrios Vibrio cholerae Cause Cholera Classical type V. cholerae V. parahaemolyticus cause Gastroenteritis El-Tor-type V. El-Tor Allied vibrios Saprophytic

Vibrio cholerae: Pacini in 1854 obseved this microorganism, and Robet Koch in 1883 described it as a comma-shaped m. o. Vibrios have 2 important antigens; H (shared), and O (specific) which is lipopolysaccharides. There at least 139 O - antigen groups. Vibrio cholerae of O group 1 (o 1) and 139 (O 139) cause the classical disease cholera, while the non-O 1/ non-O 139 V. cholerae cause cholera-like disease. Both O 1 and O 139 V. cholerae can be of two biotypes: 1. Classical 2. El-Tor Then both biotypes can be subgrouped into serotypes according to 3 antigenic factors (A, B, and C) : Ogawa (A, B), Inaba (A, C), and Hikojima (A, B. C).

Cholera: n Transmitted to humans via contaminated food and water n Part of normal flora of brackish water and estuaries

Historical Perspective: n 1817 -1820 First Pandemic spread out of India to Europe spread from India -> Middle East (reaching Turkey & Persia) -> Far East (Singapore, Japan, Philippines) n 1829 -1851 Second pandemic Entered US through NY and New Orleans -> proceeded through entire country

Recent Cholera Pandemics 7 th pandemic: · V. cholerae O 1 biotype El Tor · Began in Asia in 1961 8 th pandemic (? ? ) · V. cholerae O 139 Bengal · Began in India in 1992 and spread to Asia, Europe and U. S.

Cholera affected countries

Classification: O 1 Antigen

Vibrio cholerae (O-1 and O-139): These m. o. are highly aerobic, very actively motile (described as shooting stars or darting motility), and Pacini and Koch were able to detect these m. o. with the help of this type of motility. The best way to detect motility is by dark-field or contrast microscopy. After a prolonged culture, the m. o. become straight (similar to enteric bacilli). These m. o. can tolerate temprature of range 18 -37.

Biochemical characteristics of V. cholerae: They ferment glucose, maltose, mannite, and sucrose with acid production only. These m. o. are respiratory (oxidase positive) and fermentative (catalase positive). They give positive cholera-red reaction on nitrate peptone medium by reducing nitrate to nitrite, and produce indol (+ve) on tryptophan medium. When the latter 2 tests are combined, red colour is also produced due to nitroso-indol when H 2 SO 4 is added. The TSI shows A/A profile (yellow colour). The optimum p. H for the growth of these m. o. is 7. 0, but they can tolerate up to 8. 5 - 9. 0. They are very sensitive to acidic p. H (less than 6), therefore, they are quite susceptible to gastric juice (a major barrier against V. cholerae). V. cholerae 0 -139 is similar to El-Tor, but it differs in being capsulated.

Culture of V. cholerae: This m. o. can be cultivated on different media: 1. Alkaline Peptone Water (APW; Sea Water): This medium is of p. H 8. 5 – 9. 0 and used for the primary (first) isolation from clinical specimens. The m. o. grow forming a surface pellicle within 8 hours. Then, from this medium the m. o. can be sub- cultured on solid media (see below). Many m. o. can not tolerate such p. H, but Pseudomonas does. 2. Thiosulfate Citrate Bile Salt Sucrose Agar (TCBS): The non-inoculated medium is olive green in colour, and contains an indicator called bromo-thymol blue. V. Cholerae is sucrose- fermenter, and due to acid production, the p. H drops and colour of the medium and colonies become yellow. Aeromonas can produce similar chages in this medium.

Cont/…culture V. cholerae 3. Tellurite Taurocholate Gelatin Agar (TTGA): On this medium the colonies show iridescence and are surrounded by cloudy zone of gelatin hydrolysis. 4. Meat Extract Agar: On this medium the colonies appear translucent green to red bronzy in colour and in old cultures the colonies become opaque and rough. 5. Taurocholate Pepton Broth: This medium can be used primary cultivation of the m. o. , then sub -cultured on other media. 6. Mac. Conkey’s Agar: V. Cholerae colonies are of non-lactose fermenters. 7. Blood Agar: El-Tor growth shows beta-haemolysis ( vesus the classical). In general, the colonies of V. cholerae are convex, smooth, granular.

Practical procedure of cultivation of V. cholerae: . 1. Direct stool examination: a. Motility: Dark field or contrast microscopy. B. Microscopical exam. : mucous, epith. cells, and large numbers of m. o. , but no pus cells are seen. c. Fluorescent antibody staining. 2. 2 ml of faeces + 20 ml APW p. H 8. 0 – 8. 5 are incubated for 5 hours. At the same time, TCBS is heavily inoculated, and left for overnight. 3. From the APW, TCBS and another APW are inoculated and left either for 5 hours or overnight. 4. The colonies are subjected to further identification (see below):

Further Identification of V. cholerae: 1. String test: A drop of 0. 5% Na-deoxycholate is mixed with a colony (? ); after 60 seconds, with a loop there will a thread of tenacious nature. If positive, it means V. cholerae. 2. Polyvalent anti-sera (anti-O 1, anti- O 139): To confirm that the V. cholerae belongs to O-1 or O-139, agglutination test with specific polyvalent sera and emulsified colonies is carried out. 3. Biochemical tests including cholera red reaction. 4. Differentiation between classical & El-Tor Biotypes: See the following Table. 5. Serotyping: by specific antisera against A, B and A antigenic factors to determine Ogawa, Inaba & Hikojima.

Table: Differentiation between Classical and El-Tor biotypes of V. cholerae. tests classical El-Tor Voges-Proskauer - + Chicken RBC Agglutination - + Polymyxin-B sensitivity (50 U) + - Group IV choleraphage sensitivity + - Bet – Haemolysis (On Blood Agar) - +

Factors of Pathogenicity of V. cholerae: 1. Adherance and Motility: The actively motile m. o. can adhere to the intestinal wall (pathogenic), and vice versa for the non-motile (non-pathogenic). V. cholerae does not usually reach to the blood stream. 2. Enterotoxin: It is an important factor in the pathogenicity of the m. o. and has a M. W. of 84000 Daltons. It is composed of of 6 light chains of 8000 Daltons each, and one heavy chain of 28000 Daltons which has 2 portions: a. Toxic portion (A 1): 98% protein, 1% lipid, and 1% CHO. b. Stabilizer portion (A 2). The A 1 portion increases the intracellular c. AMP of the intestinal epithelium. The c. AMP prevents reabsorption of Na (1 X), excretion of Na. HCO 3 (2 X), chloride and K (3 -5 X). This leads to accumulation of water in large quantities (> 20 liters/day), acidosis, hypokalaemia, and death.

Cholera: Cholera is an acute infectious disease characterized by severe vomiting and watery diarrhoea (rice water stool) resulting in dehydration and collapse. The disease is endemic in the Indian subcontinent and used to occur in world wide epidemics. Infection occurs by oral route through contaminated food or drink and 10 trillions m. o. are required to cause cholera. Source of infection is a case or a carrier who excretes the organism in the stool. The incubation period is of 1 -4 days. The organisms attach to the microvilli of the brush border of epithelial cells, where they multiply and liberate cholera enterotoxin which exerts the above mentioned effects. Convalescent carriers occur, but chronic carriers are rare. The stool contains mucous, epith. cells, large numbers of m. o. and no pus cells. .

Vibrio cholerae: Clinical Infections • Acute diarrheal disease • Spread through contaminated water, but also improperly preserved foods, including fish and seafood, milk, ice cream, and unpreserved meat • “Rice Water” stools which contains ~ 108. vibrios/ gm. – Caused by cholera toxin or choleragen • Loss of electrolytes & water – Dehydration is usual cause of death – Man is the only host

Diagnosis of cholera: A. First case in non-endemic area: Any comma-shaped motile m. o. detected in a stool sample should be thoroughly identified before giving a report as positive for cholera (see identification). B. Second case during an epidemic: In an established epidemic, cases can be diagnosed by direct stool examination mainly for motility, and immobilization by specific anti-O antisera. Then, continue the identification procedure. PCR assays have been developed for detection of cholera toxin genes. Finally, mortality from untreated cholera may reach up to 25% - 50%.

Immunity against cholera: The immunity against cholera could be achieved by: 1. Gastric juice: It is a major barrier against infection by V. cholerae. 2. Secretory Ig. A: Intestinal secretory Ig. A prevents the attachment of m. o. to the intestinal wall. 3. Vibriocidal Ig. G: Anti-toxic Ab, presents in the serum. 4. Solid immunity can stay for 3 years after infection. 5. Immunoprophylaxis: a. Heat killed vaccine: Given in 2 subcutaneous doses. It stimulate anti-bacterial and not anti-toxic antibodies. Therefore, its role in protection is questionable. b. Live oral vaccine: Protects against cholera enterotoxin, and is prepared by recombinant DNA tech. c. O-139 : New vaccine using the Bengal strain (O 139)

Identification of Vibrio cholreae ØGram stain: ØGram negative short rods, comma shaped, motil Electron Micrograph of V c Gram stain of Vibrio cholorae. Rods with single polar flag ØSerology: ØDiagnosis can be confirmed as well as serotyping done by with specific antisera (O 1, O 139 antisera)

Identification of Vibrio Differentiation between SF & NSF by Growth on TCBS • Method: – TCBS agar is inoculated with tested organism recovered from alkaline peptone water using streak plate technique – Incubate the plate in incubator at 37 C/24 hrs • Results: – SF organism appears as yellow colonies (V. cholerae) – NSF organism appears as blue to green colonies (V. parahaemolyticus) Flame & Cool 2 1 5 3 4 Flame & Cool

Treatment and control of cholera: 1. Intravenous fluid and electrolytes replacement: This is the most important part of therapy. 2. Oral anti-microbial drugs: Have a secondary role in the treatment. Tetracyclines are the most effective drugs. 3. Control: The main control measures are: a. Community and personal hygiene. b. Isolation of cases and proper disposal of sewage. c. Chemoprophylaxis by using tetracyclines for exposed persons. d. Immunoprophylaxis; see above (immunity).

Vibrio parahaemolyticus These are gram negative, motile, curved, and non-sucrose bacilli. They are halophilic (salt – loving) in tolerating 2 -11 % Na. Cl depending on their biotypes. These are marine m. o. , and cause diarrhoea in some countries with sea water as Japan. There are reports that these m. o. are detected in south Iraq (Basrah). The diarrhoea is usually a self limiting condition and may be associated with constitutional symptoms as nasea, vomiting and fever. However, some times broad spectrum anti-microbial may be required as co-trimoxazole.

Vibrio vulnificus – Found in marine environments along all coasts in the U. S. – Two categories of infections • Primary septicemia following consumption of contaminated shellfish, especially raw oysters; patients with liver dysfunction that results in increased levels of iron are predisposed • Wound infections following traumatic aquatic wound

Thank you
- Slides: 33